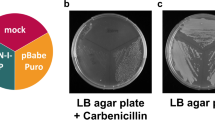

Abstract
A hybrid gene was constructed between the β-lactamase gene of plasmid pBR322 and the cloned coding sequence for rat growth hormone. This gene is expressed in bacteria and growth hormone sequences are detectable by immunological methods.
This is a preview of subscription content, access via your institution
Access options
Subscribe to this journal
Receive 51 print issues and online access
$199.00 per year
only $3.90 per issue
Buy this article
- Purchase on SpringerLink
- Instant access to full article PDF
Prices may be subject to local taxes which are calculated during checkout
Similar content being viewed by others
References
Ullrich, A. et al. Science 196, 1313–1319 (1977).
Seeburg, P. H., Shine, J., Martial, J. A., Baxter, J. D. & Goodman, H. M. Nature 270, 486–494 (1977).
Shine, J., Seeburg, P. H., Martial, J. A., Baxter, J. D. & Goodman, H. M. Nature 270, 494–499 (1977).
Goodman, H. G., Grumbach, M. M. & Kaplan, S. L. New Eng. J. Med. 278, 57–68 (1968).
Tanner, J. M., Whitehouse, R. H., Hughes, P. R. C. & Vince, F. P. Archs Dis. Child. 46, 745–782 (1971).
Winawa, S. J., Sherlock, P., Lipkin, M., Sonenberg, M. & Vanamer, P. Advances in Human Growth Hormone Research, 862–874, DHEW Publ. No. (NIH) 74–612 (1973).
Wallis, M. & Davies, R. V. in Growth Hormone and Related Polypeptides (eds Pecile, A. & Muller, E. E.) 1–14 (Elsevier, New York, 1976).
Knobil, E. & Greer, R. D. Recent Prog. Horm. Res. 15, 1–12 (1959).
Bolivar, F. Rodriguez, Betlach, M. C. & Boyer, H. W. Gene 2, 75–93 (1977).
Sutcliffe, J. G. Proc. natn. Acad. Sci. U.S.A. 75, 3737–3741 (1978).
Rodriguez, R. L., Bolivar, F., Goodman, H. M., Boyer, H. W. & Betlach, M. in ICN/UCLA Symp. Molec. Mech. Control Gene Expression (eds Nierlich, D. P., Rutter, W. J. & Fox, C. F.) 471–477 (Academic, New York, 1976).
Roozen, K. J., Fenwick, R. G. Jr. & Curtis, R., III J. Bact. 107, 21–33 (1971).
Adler, H. I., Fischer, W. D., Cohen, A. & Hardigrer, A. A. Proc. natn. Acad. Sci. U.S.A. 57, 321–326 (1966).
Leammli, U. K. Nature 227, 680–685 (1970).
Neu, H. C. & Hepel, L. A. J. biol. Chem. 240, 3685–3692 (1965).
Ivarie, R. D. & Morris, J. A. (in preparation).
Broome, S. & Gilbert, W. Proc. natn. Acad. Sci. U.S.A. 75, 2746–2749 (1978).
Miller, J. H. Experiments in Molecular Genetics (Cold Spring Harbor Laboratory, New York, 1976).
Papavasiliou, S. S., Martial, J. A., Latham, K. R. & Baxter, J. D. J. clin. Invest. 60, 1230–1239 (1977).
Villa-Komaroff, L. et al. Proc. natn. Acad. Sci. U.S.A. 75, 3727–3731 (1978).
Itekura, K. et al. Science 198, 1056–1063 (1977).
Author information
Authors and Affiliations
Rights and permissions
About this article
Cite this article
Seeburg, P., Shine, J., Martial, J. et al. Synthesis of growth hormone by bacteria. Nature 276, 795–798 (1978). https://doi.org/10.1038/276795a0
Received:
Accepted:
Published:
Issue date:
DOI: https://doi.org/10.1038/276795a0
This article is cited by
-
Predicting the Solubility of Recombinant Proteins in Escherichia coli
Nature Biotechnology (1991)
-
Amplification of maize ribulose bisphosphate carboxylase large subunit synthesis in E. coli by transcriptional fusion with the lambda N operon
Molecular and General Genetics MGG (1982)
-
Expression in E. coli of maize and wheat chloroplast genes for large subunit of ribulose bisphosphate carboxylase
Nature (1981)